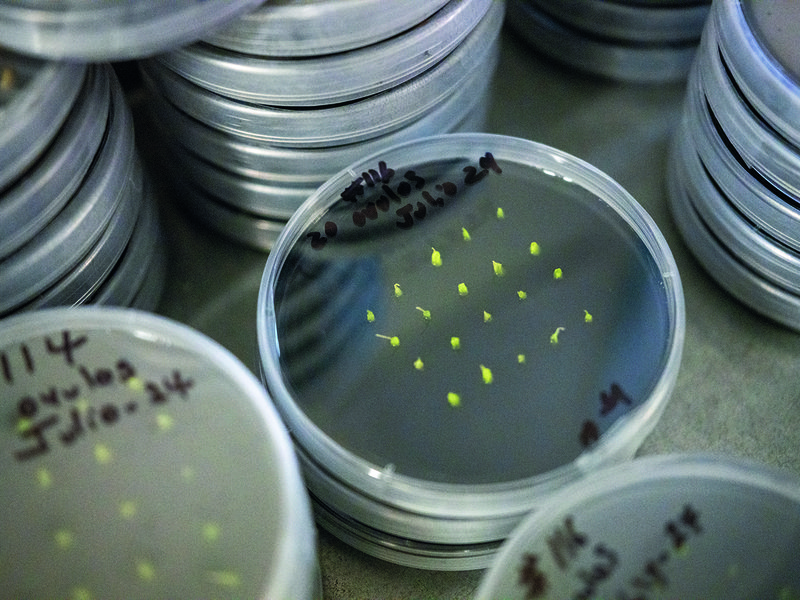
Stella Bella® grapes │ Marko Zaninovich │ Sunview runs its own highly successful breeding programme │ In the vineyards at sunrise│ Sparkle® grapes │ Pickers choose grapes for flavour

They call it “The Grapevine” – a fateful stretch of California’s I-5 highway leading into the Central Valley north of Los Angeles. The name comes from the thick, wild overgrowth of Cimarron grapes through which pioneers had to hack a path for their wagons in the 1800s. Many more grape varieties are now grown deep inside that territory and Sunview Vineyards has occupied a prime spot at the south end of the San Joaquin Valley for almost a century.
Standing in the shade of an upright gable vine and wearing something like a cowboy hat, third-generation table grape farmer Marko Zaninovich recounts how his grandfather and namesake travelled across the world from Croatia with his brothers in the 1930s. In the bare details, it’s a classic American immigration story.
“He was the youngest of 10 and he came looking for opportunity,” says Marko. “He was hungry.” Weather-wise, this particularly warm and dry pocket of inland California is optimal for production of table grapes, but farming back in those days was a precarious enterprise and the brothers could not make enough money to support the entire clan.
Most went their own way, says Marko, but his grandfather stuck at it here in Sunview. By the mid-1960s, his father had inherited a viable business which Marko and his own children, as well as nieces and nephews, have since been able to grow much further.
“We’ve found that we could really take advantage of export opportunities and the development of domestic retail developed in the US.” As things now stand, the harvest begins in July and moves up the valley as the season progresses, with certain conventionally and organically-grown grapes becoming ripe and ready later in summer and into the autumn. Cold storage and refrigerated containers allow for shipping right up to Christmastime and buyers at Spinneys have come to rely on Sunview as a trusted partner.
Two varieties stand out for being both especially tasty and entirely proprietorial. The green grape Stella Bella® and the red grape Sparkle® were created here at Sunview and are only available from this single source. They’re the fruits of a plant breeding programme that Marko’s father began back in the 1970s. “The process of crossing and evaluating is very time consuming,” he says. “You’re always looking for better flavours and colours.”
Marko continues, “You also want something more efficient, that requires less management, so you’re not always having to manipulate the cluster or the crop size prior to packaging. Every time you do that, you risk a puncture or something else that would cause a bad arrival. Our goal is a good arrival.”
He goes on to detail what this means, at the level of the individual grape. “For consumers that may not understand this, that goal is something appealing to the palate, with a neutral flavour yet sweet and crunchy and with a brilliant colour behind it. Not a dark or faded green, or a dark purple for red grapes, but bright with a little bit of finish and a full green stem. The texture should have some meat in the berry, more fibrous than watery, almost like a piece of watermelon that is solid but breaks apart easily in the mouth.”
Stella Bella® and Sparkle® are prime examples, but they took “an awful long time” to perfect – the development period from inception to planting to producing at scale being 15 years or so in the case of the former. Marko’s mother suggested those catchy names. “We’ve tried competitions to name our grapes, but my mom comes up with great ones. She usually has a lot to say and if something is not good she’ll point it out. Our company is about straight talk and if something needs improving we’re going to get behind it and give it our all.”
Creating and investing in new varieties is just one of many risks inherent in table grape farming. There are others even harder to mitigate because of factors more difficult to manage – not least the weather and the water in this ever more drought-prone landscape. “The number one challenge for us is dealing with climactic issues beyond our control. We usually have the privilege of surface water to irrigate the crops and when we don’t we can extract from an underground aquifer. It’s a huge advantage, especially in dry spells.”
But conditions aren’t becoming any more hospitable to grape-growers, and for Marko and family the word “sustainability” has come to encompass the whole concept of a workable future. “Sustainability, to me, is about being here tomorrow, as a business and as a family. It’s about water availability, air quality, packaging management and as things get more complicated, it’s going to be environmental resources, solar projects and what we need to do about dust. Organic farming is a certainly a sustainable strategy, especially as more consumers become aware of pesticides and that means really going back to the basics of farming.”
Marko maintains a sunny disposition though and radiates the evident pride of a man fully committed to his livelihood and legacy. He surveys the tall and sinuous threads of healthy grapevines all around him in his homestead. “This is where I like to spend my time, working and planning and figuring out where we’re going to be in 10 or 15 years.”

Produce commercial manager
Neil Gibson says
We were recently in Sunview Vineyards at sunrise and it was stunning! It was great to see the scale of the farm, meet the growers, eat crisp and juicy grapes right off the vine, see a range of new varieties and chat about how we can develop our business with the Zaninovich family. California really does have one of the best climates in the world to grow grapes and it’s where some of the best varieties are being bred. What we really like about Sunview is that we can source conventional and organic grapes, both of which are of superior quality.